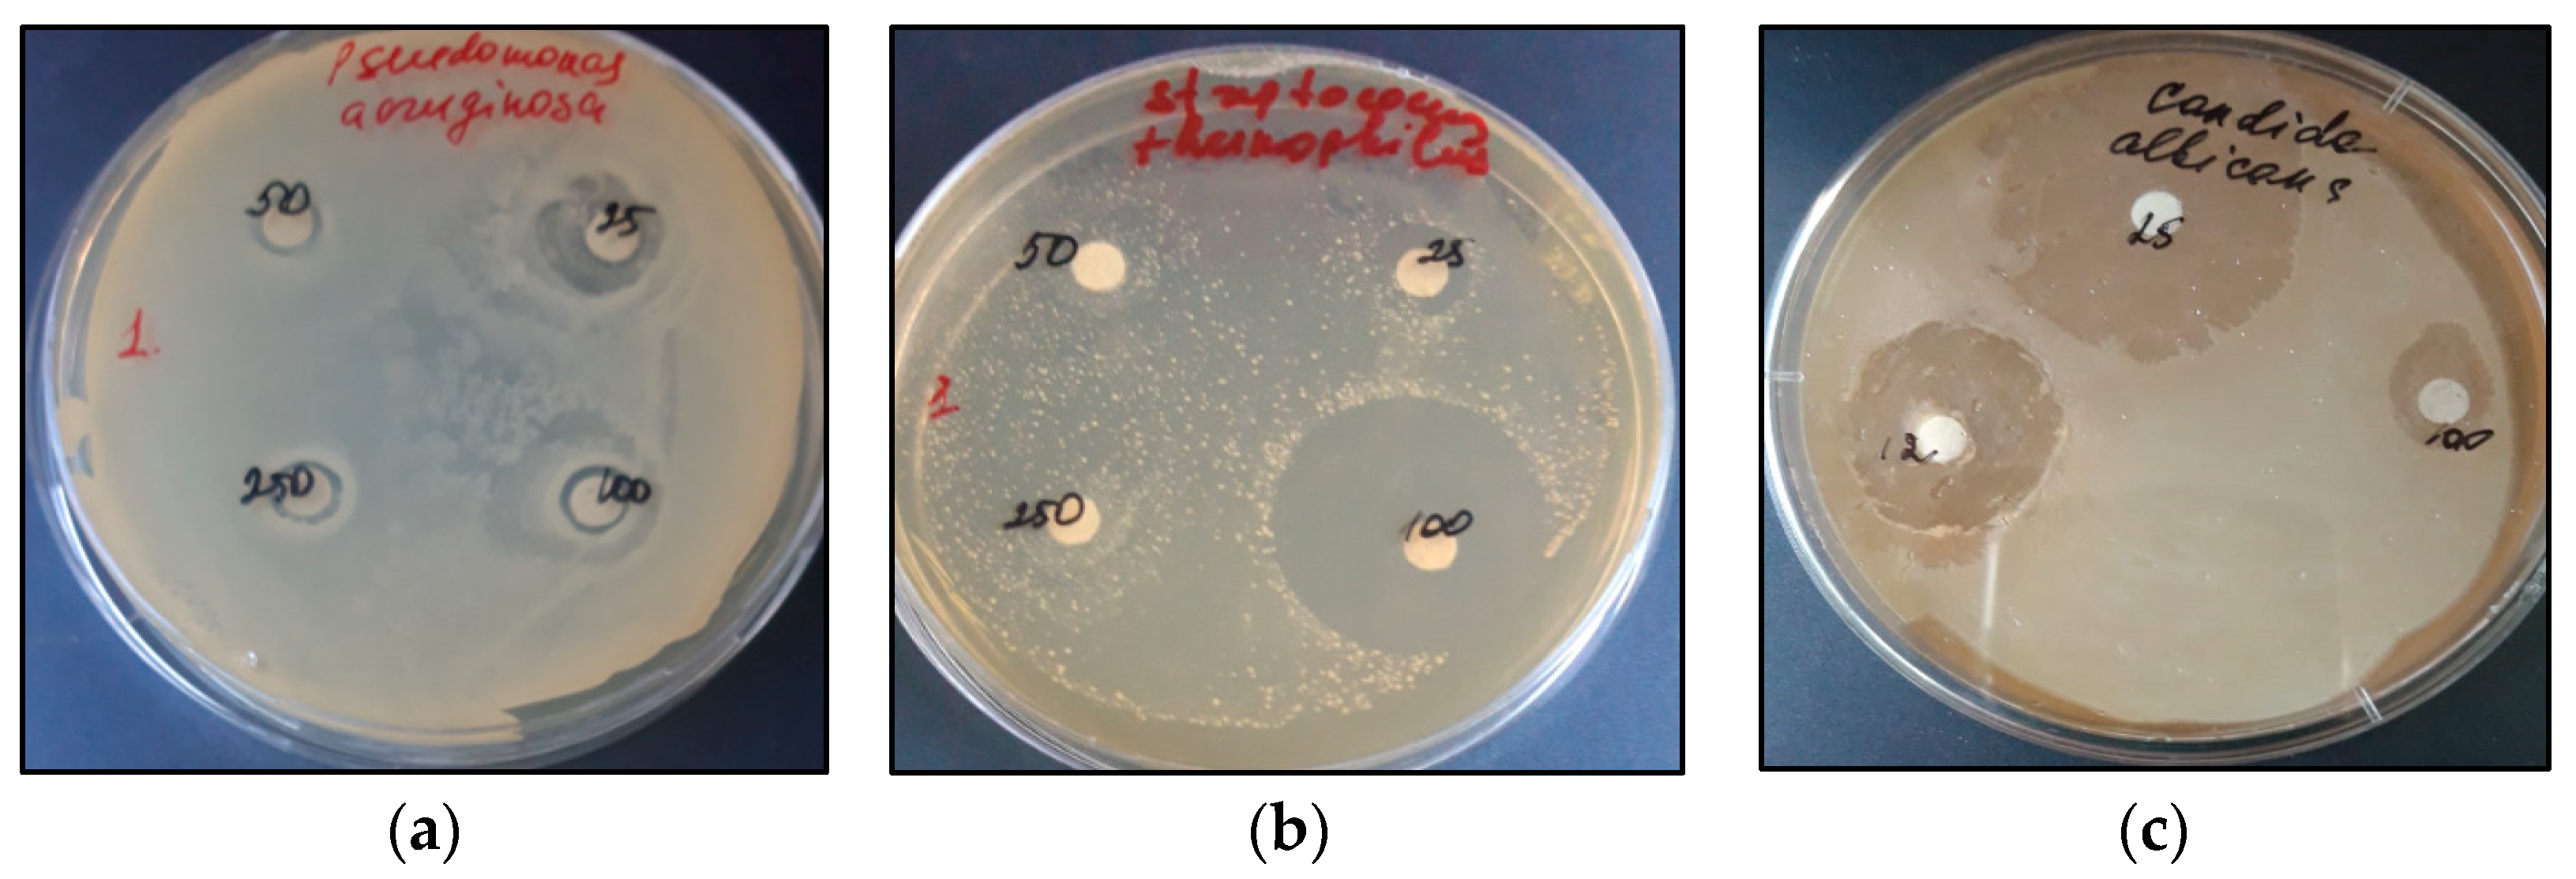

Total Content of Saponins, Phenols and Flavonoids and Antioxidant and Antimicrobial Activity of In Vitro Culture of Allochrusa gypsophiloides (Regel) Schischk Compared to Wild Plants
Abstract
1. Introduction
2. Results and Discussion
2.1. Content of Secondary Metabolites in In Situ and Ex Situ Extracts
2.2. In Vitro Adventitious Roots Culture
2.3. In Vitro Adventitious Shoot Culture
2.4. Antioxidant Activity of Extracts
2.5. Antibacterial and Antifungal Activities of TSR Extracts
3. Materials and Methods
3.1. Plant Material In Situ and Ex Situ
3.2. In Vitro Culture Plant Material
3.3. Obtaining Total Extractions
3.4. Quantitative Determination of Secondary Metabolites
3.5. DPPH Radical Scavenging Assay
3.6. Antimicrobial Activity of Total Extracts
3.7. Statistical Analysis
4. Conclusions
Author Contributions
Funding
Data Availability Statement
Conflicts of Interest
Appendix A
| Variant of ½ MS Medium | Culture Duration (Days) | FW (g/Flask) | DW (g/Flask) | GI |
|---|---|---|---|---|
| Control * | 25 | 0.97 ± 0.05 a | 0.10 ± 0.01 a | 126.55 ± 6.67 a |
| 45 | 2.66 ± 0.30 b | 0.25 ± 0.01 b | 348.31 ± 32.51 b | |
| 60 | 1.37 ± 0.02 c | 0.14 ± 0.01 c | 179.56 ± 2.92 c | |
| IBA | 25 | 1.36 ± 0.05 c | 0.12 ± 0.01 ac | 177.58 ± 6.87 c |
| 45 | 3.49 ± 0.26 b | 0.40 ± 0.03 d | 457.59 ± 27.43 b | |
| 60 | 1.62 ± 0.04 c | 0.18 ± 0.01 ac | 212.38 ± 7.44 c | |
| NAA | 25 | 1.03 ± 0.03 a | 0.10 ± 0.01 a | 134.80 ± 4.25 a |
| 45 | 1.06 ± 0.02 a | 0.09 ± 0.01 a | 140.51 ± 2.95 a | |
| 60 | 4.48 ± 0.06 d | 0.43 ± 0.04 d | 588.92 ± 7.97 d |
| In Vitro Culture | Day of Culture | ½ MS, mg/L | Total Content (% w/w) | AOA ** | |||
|---|---|---|---|---|---|---|---|
| TS | TP | TF | % | ICO50 (mg/mL) | |||
| In vitro ARs | 25 | control * | 10.39 ± 2.03 abcd | 1.15 ± 0.07 a | 0.78 ± 0.04 a | ND | ND |
| IBA | 7.96 ± 0.09 b | 1.50 ± 0.09 b | 0.78 ± 0.08 a | ND | ND | ||
| NAA | 11.44 ± 0.83 a | 1.58 ± 0.08 b | 0.62 ± 0.05 a | ND | ND | ||
| 45 | control | 27.74 ± 1.10 e | 1.41 ± 0.12 ab | 1.58 ± 0.08 b | 47.87 | 1.07 ± 0.10 bc | |
| IBA | 12.03 ± 0.04 c | 1.42 ± 0.04 b | 0.87 ± 0.04 a | 32.48 | 1.53 ± 0.17 cd | ||
| NAA | 14.59 ± 0.20 d | 1.69 ± 0.07 b | 0.34 ± 0.02 c | 26.36 | 1.87 ± 0.16 ad | ||
| 60 | control | 20.83 ± 0.55 f | 0.84 ± 0.04 c | 0.72 ± 0.03 a | 38.68 | 1.36 ± 0.12 cd | |
| IBA | 17.64 ± 0.42 g | 2.12 ± 0.09 d | 0.77 ± 0.03 a | 39.07 | 1.33 ± 0.08 c | ||
| NAA | 16.66 ± 0.63 g | 0.29 ± 0.01 e | 0.45 ± 0.01 d | 27.07 | 1.79 ± 0.14 ad | ||
| In vitro ASs | 30 | MS | 7.69 ± 0.33 b | 2.63 ± 0.10 g | 1.94 ± 0.04 e | 34.38 | 1.62 ± 0.18 acd |
| Source | df | Sum of Squares (SS) | Mean Square (MS) | F-Value | p-Value | η2% (ICC) |
|---|---|---|---|---|---|---|
| GI | ||||||
| A | 2 | 184,141 | 92,070 | 140 | <0.001 | 27.62 |
| B | 2 | 27,199 | 13,600 | 20,68 | <0.001 | 4.08 |
| AB | 4 | 443,412 | 110,853 | 168.57 | <0.001 | 66.52 |
| Error | 18 | 11,837 | 658 | |||
| Total | 26 | 666,588 | ||||
| TS | ||||||
| A | 2 | 416.13 | 208.06 | 134.92 | <0.001 | 45.35 |
| B | 2 | 248.25 | 124.12 | 80.48 | <0.001 | 27.05 |
| AB | 4 | 225.52 | 56.38 | 36.56 | <0.001 | 24.56 |
| Error | 18 | 27.76 | 1.54 | |||
| Total | 26 | 917.66 | ||||
| TP | ||||||
| A | 2 | 0.88 | 0.44 | 38.06 | <0.001 | 12.94 |
| B | 2 | 1.64 | 0.82 | 70.69 | <0.001 | 24.02 |
| AB | 4 | 4.11 | 1.03 | 88.24 | <0.001 | 59.98 |
| Error | 18 | 0.20 | 0.01 | |||
| Total | 26 | 6.85 | ||||
| TF | ||||||
| A | 2 | 0.38 | 0.19 | 40.25 | <0.001 | 12.88 |
| B | 2 | 1.39 | 0.89 | 145.47 | <0.001 | 46.54 |
| AB | 4 | 1.13 | 0.28 | 58.92 | <0.001 | 37.70 |
| Error | 18 | 0.08 | 0.00 | |||
| Total | 26 | 2.98 |
References
- Bykov, B.A. (Ed.) Red Data Book of the Kazakh SSR; Science: Alma-Ata, Kazakhstan, 1981. [Google Scholar]
- Eisenman, S.W.; Zaurov, D.E.; Struwe, L. Medicinal Plants of Central Asia: Uzbekistan and Kyrgyzstan; Springer Science & Business Media: Berlin/Heidelberg, Germany, 2012. [Google Scholar]
- Balandrin, M.F. Commercial Utilization of Plant-Derived Saponins: An Overview of Medicinal, Pharmaceutical, and Industrial Applications. In Saponins Used in Traditional and Modern Medicine; Springer: Berlin/Heidelberg, Germany, 1996; pp. 1–14. [Google Scholar] [CrossRef]
- Putieva, Z.M.; Gorovich, T.T.; Kondratenko, E.S.; Abubakirov, N.K. Triterpene glycosides of Acanthophllum gypsophiloides VI. Structure of Acanthophylloside D. Chem. Nat. Compd. 1979, 15, 148–151. [Google Scholar] [CrossRef]
- Khatuntseva, E.A.; Men’shov, V.M.; Shashkov, A.S.; Tsvetkov, Y.E.; Stepanenko, R.N.; Vlasenko, R.Y.; Shults, E.E.; Tolstikov, G.A.; Tolstikova, T.G.; Baev, D.S.; et al. Triterpenoid Saponins from the Roots of Acanthophyllum gypsophiloides Regel. Beilstein J. Org. Chem. 2012, 8, 763–775. [Google Scholar] [CrossRef] [PubMed]
- Khushbakatova, Z.A.; Putiyeva, Z.M.; Syrov, V.N.; Kruglikov, B.A.; Tarasenko, T.Y.; Salazhov, Y.L. Adjuvant Activity of Some Triterpenic Saponins. Khimiko-Farmatsevticheskii Zhurnal 1993, 27, 48–52. [Google Scholar]
- Mamadalieva, R.Z.; Sharopov, F.S.; Ibragimov, A.A.; Abdullaev, S.V.; Khujaev, V.U. Chemical Composition and in vitro Biological Activities of Essential Oil from Allochrusa gypsophiloides. Food Ther. Health Care 2021, 3, 10–15. [Google Scholar] [CrossRef]
- Ashour, A.S.; El Aziz, M.M.A.; Gomha Melad, A.S. A Review on Saponins from Medicinal Plants: Chemistry, Isolation, and Determination. JNMR 2019, 7, 282–288. [Google Scholar] [CrossRef]
- Faizal, A.; Geelen, D. Saponins and Their Role in Biological Processes in Plants. Phytochem. Rev. 2013, 12, 877–893. [Google Scholar] [CrossRef]
- Rai, S.; Acharya-Siwakoti, E.; Kafle, A.; Devkota, H.P.; Bhattarai, A. Plant-Derived Saponins: A Review of Their Surfactant Properties and Applications. Sci 2021, 3, 44. [Google Scholar] [CrossRef]
- Fang, Z.; Li, J.; Yang, R.; Fang, L.; Zhang, Y. A Review: The Triterpenoid Saponins and Biological Activities of Lonicera Linn. Molecules 2020, 25, 3773. [Google Scholar] [CrossRef]
- Suresh, P.K. Saponins-Uptake and Targeting Issues for Brain-Specific Delivery for Enhanced Cell Death Induction in Glioblastoma. LDDD 2022, 19, 473–480. [Google Scholar] [CrossRef]
- Vincken, J.-P.; Heng, L.; De Groot, A.; Gruppen, H. Saponins, Classification and Occurrence in the Plant Kingdom. Phytochemistry 2007, 68, 275–297. [Google Scholar] [CrossRef]
- Chen, X.; Wang, Y.; Zhao, H.; Fu, X.; Fang, S. Localization and Dynamic Change of Saponins in Cyclocarya paliurus (Batal.) Iljinskaja. PLoS ONE 2019, 14, e0223421. [Google Scholar] [CrossRef] [PubMed]
- Fenwick, G.R.; Price, K.R.; Tsukamoto, C.; Okubo, K. Saponins. In Toxic Substances in Crop Plants; Elsevier: Amsterdam, The Netherlands, 1991; pp. 285–327. ISBN 978-1-85573-814-0. [Google Scholar]
- Bespaev, S.B. Acanthophyllum gypsophiloides in Kazakhstan: Morphology, Taxonomy, Phytosociology, Testing in Culture. Abstract Thesis on the Scientific Degree of Candidate of Biological Sciences; Republican Printing House: Almaty, Kazakhstan, 1966. [Google Scholar]
- Gladyshev, A.I.; Mishchenko, A.S.; Kerbabaev, B.B. Koliuchelistniki Turkmenistana Ikh Biologiia I Perspektivy Khoziaistvennogo Ispol’zovaniia; Ylym: Ashkhabad, Turkmenistan, 1990; ISBN 978-5-8338-0165-9. [Google Scholar]
- Arifkhodzhaev, A.O. Polysaccharides of Saponin-Bearing Plants VIII. Structural Investigation of a Glucogalactan from the Roots of Allochrusa gypsophiloides. Chem. Nat. Compd. 1996, 32, 523–525. [Google Scholar] [CrossRef]
- Mamadalieva, R.; Khujaev, V.; Šoral, M.; Mamadalieva, N.Z.; Wink, M. The Genus Allochrusa: A Comprehensive Review of Botany, Traditional Uses, Phytochemistry, and Biological Activities. Diversity 2023, 15, 574. [Google Scholar] [CrossRef]
- Gemejiyeva, N.G.; Mursaliyeva, V.K.; Mukhanov, T.M. Assessment of the Current State of Allochrusa gypsophiloides (Regel) Schischk. Natural Populations in the South-Kazakhstan Region. News Natl. Acad. Sci. Repub. Kazakhstan Ser. Biol. Med. 2016, 1, 22–29. [Google Scholar]
- Espinosa-Leal, C.A.; Puente-Garza, C.A.; García-Lara, S. In vitro Plant Tissue Culture: Means for Production of Biological Active Compounds. Planta 2018, 248, 1–18. [Google Scholar] [CrossRef]
- Gantait, S.; Mitra, M.; Chen, J.-T. Biotechnological Interventions for Ginsenosides Production. Biomolecules 2020, 10, 538. [Google Scholar] [CrossRef]
- Rahmat, E.; Kang, Y. Adventitious Root Culture for Secondary Metabolite Production in Medicinal Plants: A Review. J. Plant Biotechnol. 2019, 46, 143–157. [Google Scholar] [CrossRef]
- Hussain, M.J.; Abbas, Y.; Nazli, N.; Fatima, S.; Drouet, S.; Hano, C.; Abbasi, B.H. Root Cultures, a Boon for the Production of Valuable Compounds: A Comparative Review. Plants 2022, 11, 439. [Google Scholar] [CrossRef]
- Murthy, H.N. Biotechnological Production of Bacosides from Cell and Organ Cultures of Bacopa monnieri. Appl. Microbiol. Biotechnol. 2022, 106, 1799–1811. [Google Scholar] [CrossRef]
- Thi Thuy Tien, L. Root Cultures for Secondary Products. In Plant Roots; Yildirim, E., Turan, M., Ekinci, M., Eds.; IntechOpen: London, UK, 2021; ISBN 978-1-83968-266-7. [Google Scholar]
- Khanam, M.N.; Anis, M.; Javed, S.B.; Mottaghipisheh, J.; Csupor, D. Adventitious Root Culture—An Alternative Strategy for Secondary Metabolite Production: A Review. Agronomy 2022, 12, 1178. [Google Scholar] [CrossRef]
- Sanyal, R.; Nandi, S.; Pandey, S.; Chatterjee, U.; Mishra, T.; Datta, S.; Prasanth, D.A.; Anand, U.; Mane, A.B.; Kant, N.; et al. Biotechnology for Propagation and Secondary Metabolite Production in Bacopa monnieri. Appl. Microbiol. Biotechnol. 2022, 106, 1837–1854. [Google Scholar] [CrossRef] [PubMed]
- Di Cola, A.; Di Domenico, C.; Poma, A.; Spanò, L. Saporin Production from in vitro Cultures of the Soapwort Saponaria officinalis L. Plant Cell Rep. 1997, 17, 55–59. [Google Scholar] [CrossRef] [PubMed]
- Fulcheri, C.; Morard, P.; Henry, M. Stimulation of the Growth and the Triterpenoid Saponin Accumulation of Saponaria officinalis Cell and Gypsophila paniculata Root Suspension Cultures by Improvement of the Mineral Composition of the Media. J. Agric. Food Chem. 1998, 46, 2055–2061. [Google Scholar] [CrossRef]
- Gevrenova, R.; Stancheva, T.; Voynikov, Y.; Laurain-Mattar, D.; Henry, M. Root in vitro Cultures of Six Gypsophila Species and Their Saponin Contents. Enzym. Microb. Technol. 2010, 47, 97–104. [Google Scholar] [CrossRef]
- Langhansová, L.; Marsík, P.; Vanĕk, T. Alternative production of saponins from panax ginseng. Acta Hortic. 2005, 4, 45–50. [Google Scholar] [CrossRef]
- Choi, S.M.; Ho Son, S.; Rho Yun, S.; Woung Kwon, O.; Hoon Seon, J.; Yoeup Paek, K. Pilot-Scale Culture of Adventitious Roots of Ginseng in a Bioreactor System. Plant Cell Tissue Organ Cult. 2000, 62, 187–193. [Google Scholar] [CrossRef]
- Sarropoulou, V.; Sarrou, E.; Angeli, A.; Martens, S.; Maloupa, E.; Grigoriadou, K. Species-Specific Secondary Metabolites from Primula veris Subsp. veris Obtained in vitro Adventitious Root Cultures: An Alternative for Sustainable Production. Sustainability 2023, 15, 2452. [Google Scholar] [CrossRef]
- Akula, R.; Ravishankar, G.A. Influence of Abiotic Stress Signals on Secondary Metabolites in Plants. Plant Signal. Behav. 2011, 6, 1720–1731. [Google Scholar] [CrossRef]
- Terletskaya, N.V.; Korbozova, N.K.; Kudrina, N.O.; Kobylina, T.N.; Kurmanbayeva, M.S.; Meduntseva, N.D.; Tolstikova, T.G. The Influence of Abiotic Stress Factors on the Morphophysiological and Phytochemical Aspects of the Acclimation of the Plant Rhodiola semenowii Boriss. Plants 2021, 10, 1196. [Google Scholar] [CrossRef]
- Gaia, A.M.; Yamaguchi, L.F.; Guerrero-Perilla, C.; Kato, M.J. Ontogenetic Changes in the Chemical Profiles of Piper Species. Plants 2021, 10, 1085. [Google Scholar] [CrossRef]
- Endara, M.-J.; Soule, A.J.; Forrister, D.L.; Dexter, K.G.; Pennington, R.T.; Nicholls, J.A.; Loiseau, O.; Kursar, T.A.; Coley, P.D. The Role of Plant Secondary Metabolites in Shaping Regional and Local Plant Community Assembly. J. Ecol. 2022, 110, 34–45. [Google Scholar] [CrossRef]
- Rachkovskaya, E.I.; Volkova, E.A.; Khramtsov, V.N. Botanical Geography of Kazakhstan and Middle Asia (within the Desert Zone); Science: St. Petersburg, Russia, 2003. [Google Scholar]
- Mursaliyeva, V.; Algasy, A.; Mukhanov, T.; Mammadov, R.; Gemejïyeva, N. Quantitative Determination of Metabolites of Turkestan Soaproot (Allochrusa gypsophiloides (Regel) Schischk.) Grown in Kazakhstan. Int. J. Nat. Life Sci. 2022, 6, 129–141. [Google Scholar] [CrossRef]
- Kondratenko, E.S.; Putieva, Z.M.; Abubakirov, N.K. Triterpene Glycosides of Plants of the Family Caryophyllaceae. Chem. Nat. Compd. 1981, 17, 303–317. [Google Scholar] [CrossRef]
- Shadrin, D.M.; Pylina, Y.I.; Volodina, S.O.; Volodin, V. Analysis of Plants Anthyllis vulneraria L. Growing in the European Northeast of Russia. Izvestiya of the Samara Scientific Center of the RAS. Izv. Samara Sci. Cent. Russ. Acad. Sci. 2011, 13, 945–947. [Google Scholar]
- Chrevach, E.; Yudina, T.; Frolova, G.; Zhivchikova, R. Dynamics and Biological Activity Saponins in Extracts from Roots Saponaria officinalis L. Izvestiya Vuzov. Food Technology Growing in the European Northeast of Russia. Izvestiya of the Samara Scientific Center of the RAS, 2—Search in Google. Available online: https://cyberleninka.ru/article/n/dinamika-i-biologicheskaya-aktivnost-saponinov-v-ekstraktah-iz-korney-mylnyanki-saponaria-officinalis-l (accessed on 3 September 2023).
- Fedoseeva, L.M.; Bashar, D.B. Study of Saponins in Underground Organs of Chermona Ferula. JCPRM 2015. [Google Scholar] [CrossRef][Green Version]
- Pisarev, D.I.; Martynova, N.A.; Netrebko, N.N.; Novikov, O.O.; Sorokopudov, V.N. Saponins and Their Definition in the Rhizomes Aralia Manchurian from the Belgorod Region. Himija Rastitel’nogo Syr’ja 2009, 4, 197–198. [Google Scholar]
- Maliński, M.P.; Kikowska, M.A.; Soluch, A.; Kowalczyk, M.; Stochmal, A.; Thiem, B. Phytochemical Screening, Phenolic Compounds and Antioxidant Activity of Biomass from Lychnis flos-cuculi L. In vitro Cultures and Intact Plants. Plants 2021, 10, 206. [Google Scholar] [CrossRef]
- Lee, J.-D.; Hyun, H.B.; Hyeon, H.; Jang, E.; Ko, M.-H.; Yoon, W.-J.; Ham, Y.M.; Jung, Y.-H.; Choi, H.; Gene O, E.; et al. Mass Proliferation of Hibiscus hamabo Adventitious Root in an Air-Lift Bioreactor, and the Antioxidant and Whitening Activity of the Extract. Korean J. Plant Resour. 2022, 35, 435–444. [Google Scholar] [CrossRef]
- Singh, R.; Chaturvedi, P. In vitro Propagation and Establishment of Adventitious Root Cultures of Rheum emodi Wall. Ex Meisn for Quantification of Emodin Production. In Vitro Cell. Dev. Biol. Plant 2022, 58, 80–92. [Google Scholar] [CrossRef]
- Simão, M.J.; Fonseca, E.; Garcia, R.; Mansur, E.; Pacheco, G. Effects of Auxins and Different Culture Systems on the Adventitious Root Development of Passiflora pohlii Mast. and Their Ability to Produce Antioxidant Compounds. Plant Cell Tissue Organ Cult. 2016, 124, 419–430. [Google Scholar] [CrossRef]
- AdïL, M.; Abbasï, B.H. Adventitious Roots Formation for Enhanced and Sustainable Production of Antioxidants in Brassica oleracea Var. Acephala (Brassicaceae). Int. J. Second. Metab. 2019, 6, 162–171. [Google Scholar] [CrossRef]
- Okršlar, V.; Plaper, I.; Kovač, M.; Erjavec, A.; Obermajer, T.; Rebec, A.; Ravnikar, M.; Žel, J. Saponins in Tissue Culture of Primula veris L. In Vitro Cell. Dev. Biol. Plant 2007, 43, 644–651. [Google Scholar] [CrossRef]
- Demirci, T.; Albayrak, İ.; Göktürk Baydar, N. L-Phenylalanine Applications and Culture Duration Affect Root Growth and Production of Tropane Alkaloids and Phenolics in Adventitious Root Cultures of Hyoscyamus niger L. Plant Cell Tissue Organ Cult. 2022, 149, 295–311. [Google Scholar] [CrossRef]
- Devecï, H.; DemïRcï, T.; Göktürk Baydar, N. Effect of Culture Time on Secondary Metabolite Production from MeJA-Stimulated in vitro Roots of Hyoscyamus niger L. Int. J. Second. Metab. 2022, 9, 178–193. [Google Scholar] [CrossRef]
- Anh, T.T.L.; Tung, H.T.; Khai, H.D.; Mai, N.T.N.; Luan, V.Q.; Cuong, D.M.; Phuong, H.T.N.; Diem, L.T.; Vinh, N.Q.; Dung, D.M.; et al. Micropropagation of Lang Bian Ginseng: An Endemic Medicinal Plant. Plant Cell Tissue Organ Cult. 2022, 151, 565–578. [Google Scholar] [CrossRef]
- Luthra, R.; Roy, A.; Pandit, S.; Prasad, R. Biotechnological Methods for the Production of Ginsenosides. S. Afr. J. Bot. 2021, 141, 25–36. [Google Scholar] [CrossRef]
- Kalasnikova, E.A.; Khuat, Q.V.; Kirakosyan, R.N. Effect of Plant Growth Regulators on in vitro Plant Regeneration of Purple Amomum Amomum longiligulare T.L. Wu. Russ. J. Plant Physiol. 2022, 69, 168. [Google Scholar] [CrossRef]
- Khan, A.; Shah, A.H.; Ali, N. In-Vitro Propagation and Phytochemical Profiling of a Highly Medicinal and Endemic Plant Species of the Himalayan Region (Saussurea costus). Sci. Rep. 2021, 11, 23575. [Google Scholar] [CrossRef]
- Pant, H.C.; Rautela, I.; Pant, H.V.; Kumar, A.; Kumar, P.; Fatima, K.; Gaurav, N. Comparison of Antioxidant Properties and Flavonoid of Natural and In Vitro Cultivated Nardostachys jatamansi. ASD 2023. [Google Scholar] [CrossRef]
- Muraseva, D.S.; Kostikova, V.A. In vitro Propagation of Spiraea betulifolia Subsp. Aemiliana (Rosaceae) and Comparative Analysis of Phenolic Compounds of Microclones and Intact Plants. Plant Cell Tissue Organ Cult. 2021, 144, 493–504. [Google Scholar] [CrossRef]
- Yildirim, A.; Uyar, E.; Turker, A. In Vitro Culture of Endemic Astragalus gymnolobus Fischer and Comparison of Its Antibacterial, Antioxidant, and Phenolic Profiles with Field Grown Plants. J. Agric. Sci. Technol. 2020, 22, 815–828. [Google Scholar]
- Mursaliyeva, V.; Imanbayeva, A. Micropropagation of Turkestan Soap Root Allochrusa gypsophiloides—Natural Source of Saponins. Int. J. Second. Metab. 2020, 7, 1–7. [Google Scholar] [CrossRef][Green Version]
- Lugato, D.; Simão, M.J.; Garcia, R.; Mansur, E.; Pacheco, G. Determination of Antioxidant Activity and Phenolic Content of Extracts from in vivo Plants and in vitro Materials of Passiflora Alata Curtis. Plant Cell Tissue Organ Cult. 2014, 118, 339–346. [Google Scholar] [CrossRef]
- Yang, R.; Dong, Y.; Gao, F.; Li, J.; Stevanovic, Z.D.; Li, H.; Shi, L. Comprehensive Analysis of Secondary Metabolites of Four Medicinal Thyme Species Used in Folk Medicine and Their Antioxidant Activities in vitro. Molecules 2023, 28, 2582. [Google Scholar] [CrossRef]
- Sochacki, M.; Vogt, O. Triterpenoid Saponins from Washnut (Sapindus mukorossi Gaertn.)—A Source of Natural Surfactants and Other Active Components. Plants 2022, 11, 2355. [Google Scholar] [CrossRef]
- Salazar-Magallón, J.A.; Huerta De La Peña, A. Production of Antifungal Saponins in an Airlift Bioreactor with a Cell Line Transformed from Solanum chrysotrichum and Its Activity against Strawberry Phytopathogens. Prep. Biochem. Biotechnol. 2020, 50, 204–214. [Google Scholar] [CrossRef]
- Hu, Q.; Chen, Y.-Y.; Jiao, Q.-Y.; Khan, A.; Li, F.; Han, D.-F.; Cao, G.-D.; Lou, H.-X. Triterpenoid Saponins from the Pulp of Sapindus mukorossi and Their Antifungal Activities. Phytochemistry 2018, 147, 1–8. [Google Scholar] [CrossRef] [PubMed]
- Moghimipour, E.; Sadaghi-Nejad, B.; Handali, S.; Ameri, A.; Ramezani, Z.; Azemi, M.E. In Vitro Screening of Anti-Candida Activity of Saponins Extracted from Glycyrrhiza glabra and Quillaja saponaria. Asian J. Pharm. Clin. Res. 2014, 7, 160–162. [Google Scholar]
- Mursaliyeva, V.; Imanbayeva, A.; Parkhatova, R. Seed Germination of Allochrusa gypsophiloides (Caryophyllaceae), an Endemic Species from Central Asia and Kazakhstan. Seed Sci. Technol. 2020, 48, 289–295. [Google Scholar] [CrossRef]
- Mursaliyeva, V.; Algazy, A.; Satybaldiyeva, D.; Mukhanov, T. Obtaining of Adventitious Roots Culture of Allochrusa gypsophiloides: Saponins-Bearing Endemic Rare Species. Plant Biotechnol. Rep. 2023, 17, 421–425. [Google Scholar] [CrossRef]
- Kovalev, V.N.; Popova, N.V.; Kislichenko, V.S.; Isakova, T.I.; Zhuravel, I.O.; Stepanova, S.I.; Serbin, A.G.; Sira, L.M.; Kartmazova, L.S. Workshop on Pharmacognosy; NUPh Publising House: Kharkov, Ukraine, 2003. [Google Scholar]
- Oganesyan, É.T. Mechanism of the Reaction of Triterpenoids with Sulfuric Acid. Chem. Nat. Compd. 1980, 16, 464–468. [Google Scholar] [CrossRef]
- Jain, D.; Shrivastava, S. Estimation of Total Phenolic, Flavonoid and Saponin Content in Different Extracts of Butea monosperma Bark. Int. J. Eng. Technol. Sci. Res. 2017, 4, 177–182. [Google Scholar]
- Türkoğlu, S.; Çelik, S.; Türkoğlu, I.; Çakılcıoğlu, U.; Bahsi, M. Determination of the Antioxidant Properties of Ethanol and Water Extracts from Different Parts of Teucrium parviflorum Schreber. Afr. J. Biotechnol. 2010, 9, 6797–6805. [Google Scholar] [CrossRef]
- Chang, C.-C.; Yang, M.-H.; Wen, H.-M.; Chern, J.-C. Estimation of Total Flavonoid Content in Propolis by Two Complementary Colorimetric Methods. J. Food Drug Anal. 2002, 10, 3. [Google Scholar] [CrossRef]
- Hossein Goli, S.A.; Mokhtari, F.; Rahimmalek, M. Phenolic Compounds and Antioxidant Activity from Saffron (Crocus sativus L.) Petal. JAS 2012, 4, 175. [Google Scholar] [CrossRef][Green Version]
- Singh, B.; Sahu, P.M.; Sharma, M.K. Anti-Inflammatory and Antimicrobial Activities of Triterpenoids from Strobilanthes callosus Nees. Phytomedicine 2002, 9, 355–359. [Google Scholar] [CrossRef]
- State Pharmacopoeia of the RF; XII; Ministry of Health of the RF: Moscow, Russia, 2010; Volume 2.

| Part of the Plant | Conditions, Vegetation Phase | Total Content, % w/w | AOA | |||
|---|---|---|---|---|---|---|
| TS | TP | TF | % | ICO50 (mg/mL) | ||
| Root | in situ * | 13.55 ± 0.40 ab | 2.83 ± 0.08 a | 0.46 ± 0.01 a | 18.47 | 2.46 ± 0.29 a |
| ex situ ** | 12.63 ± 0.48 ab | 1.32 ± 0.06 b | 0.14 ± 0.01 b | 13.23 | 2.05 ± 0.16 a | |
| Aerial | vegetation | 16.50 ± 0.21 c | 3.54 ± 0.16 c | 2.85 ± 0.11 c | 55.79 | 0.87 ± 0.05 b |
| flowering | 14.21 ± 0.48 a | 4.17 ± 0.11 c | 8.45 ± 0.31 d | 42.28 | 1.20 ± 0.18 bc | |
| end of vegetation (“tumble-weed”) | 12.01 ± 0.41 b | 0.79 ± 0.04 d | 0.53 ± 0.03 a | 11.66 | 2.18 ± 0.16 ad | |
| Culture and Control | ½ MS | Mean Diameter of Inhibition Zones (mm) | ||||||
|---|---|---|---|---|---|---|---|---|
| µL | B. subtillis | µL | S. thermophillus | E. coli | µL | P. aeruginosa | ||
| ARs 45 day | control | - | 100 | 18.17 ± 0.76 a | - | 25 | 4.87 ± 0.23 a | |
| NAA | - | - | - | - | ||||
| IBA | - | 100 | 5.77 ± 0.25 b | - | - | |||
| ARs 60 day | control | 250 | 4.63 ± 0.15 ac | 100 | 13.33 ± 0.58 c | - | 250 | 3.80 ± 0.20 b |
| NAA | 250 | 4.57 ± 0.25 ac | - | - | - | |||
| IBA | 250 | 3.97 ± 0.21 a | - | - | - | |||
| Ethanol | 20 | - | 2.10 ± 0.10 d | - | 3.00 ± 0.1 °C | |||
| Lincomycin | 20 | 5.0 ± 0.1 °C | - | 5.0 ± 0.10 b | 9.60 ± 0.45 d | |||
| Saponin of Quillaja bark | 25 | - | - | - | - | |||
| Culture and Control | ½ MS | Mean Diameter of Inhibition Zones (mm) | |||
|---|---|---|---|---|---|
| µL | S. cerevisiae | mL | C. albicans | ||
| AR 45 day | control | 100 | 4.80 ± 0.26 a | 1.0 | 10.73 ± 0.71 a |
| NAA | - | 1.25 | 10.63 ± 0.55 a | ||
| IBA | - | NT | |||
| AR 60 day | control | 250 | 4.63 ± 0.15 a | 1.25 | 5.83 ± 0.15 b |
| NAA | - | 1.25 | 9.83 ± 0.29 a | ||
| IBA | - | 1.0 | 10.00 ± 0.50 a | ||
| ethanol, 20 µL | 4.00 ± 0.10 b | - | |||
| fluconazole, 20 µL | 9.00 ± 0.5 °C | 5.00 ± 0.1 °C | |||
| Saponin from Quillaja bark, 25 µL | 14.77 ± 0.68 d | 16.17 ± 0.76 d | |||
Disclaimer/Publisher’s Note: The statements, opinions and data contained in all publications are solely those of the individual author(s) and contributor(s) and not of MDPI and/or the editor(s). MDPI and/or the editor(s) disclaim responsibility for any injury to people or property resulting from any ideas, methods, instructions or products referred to in the content. |
© 2023 by the authors. Licensee MDPI, Basel, Switzerland. This article is an open access article distributed under the terms and conditions of the Creative Commons Attribution (CC BY) license (https://creativecommons.org/licenses/by/4.0/).
Share and Cite
Mursaliyeva, V.K.; Sarsenbek, B.T.; Dzhakibaeva, G.T.; Mukhanov, T.M.; Mammadov, R. Total Content of Saponins, Phenols and Flavonoids and Antioxidant and Antimicrobial Activity of In Vitro Culture of Allochrusa gypsophiloides (Regel) Schischk Compared to Wild Plants. Plants 2023, 12, 3521. https://doi.org/10.3390/plants12203521
Mursaliyeva VK, Sarsenbek BT, Dzhakibaeva GT, Mukhanov TM, Mammadov R. Total Content of Saponins, Phenols and Flavonoids and Antioxidant and Antimicrobial Activity of In Vitro Culture of Allochrusa gypsophiloides (Regel) Schischk Compared to Wild Plants. Plants. 2023; 12(20):3521. https://doi.org/10.3390/plants12203521
Chicago/Turabian StyleMursaliyeva, Valentina K., Balaussa T. Sarsenbek, Gulnara T. Dzhakibaeva, Tlek M. Mukhanov, and Ramazan Mammadov. 2023. "Total Content of Saponins, Phenols and Flavonoids and Antioxidant and Antimicrobial Activity of In Vitro Culture of Allochrusa gypsophiloides (Regel) Schischk Compared to Wild Plants" Plants 12, no. 20: 3521. https://doi.org/10.3390/plants12203521
APA StyleMursaliyeva, V. K., Sarsenbek, B. T., Dzhakibaeva, G. T., Mukhanov, T. M., & Mammadov, R. (2023). Total Content of Saponins, Phenols and Flavonoids and Antioxidant and Antimicrobial Activity of In Vitro Culture of Allochrusa gypsophiloides (Regel) Schischk Compared to Wild Plants. Plants, 12(20), 3521. https://doi.org/10.3390/plants12203521

